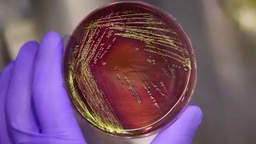

현지시간 23일 영국 런던에서 미국과 영국, 프랑스, 독일, 우크라이나 대표단이 모여 러·우 전쟁 휴전 협상안을 논의합니다.
워싱턴포스트는 런던 회담에서 미국이 러시아의 크림반도 점령을 인정하고, 현재 그어진 전선을 동결하는 것을 포함한 평화 협상안을 제시할 것이라고 전했습니다.
유럽 국가들은 대러 영토 양보안을 우크라이나가 받아들일 경우 미국의 대우크라이나 안전보장 참여 등을 희망하고 있는 것으로 전해졌습니다.
트럼프 미국 대통령의 중동 담당 특사인 스타브 위트코프는 이번 주 러시아를 방문해 블라디미르 푸틴 러시아 대통령과 만날 예정입니다.
신주원 PD
#우크라이나전쟁
연합뉴스TV 기사문의 및 제보 : 카톡/라인 jebo23
신주원(nanjuhee@yna.co.kr)
워싱턴포스트는 런던 회담에서 미국이 러시아의 크림반도 점령을 인정하고, 현재 그어진 전선을 동결하는 것을 포함한 평화 협상안을 제시할 것이라고 전했습니다.
유럽 국가들은 대러 영토 양보안을 우크라이나가 받아들일 경우 미국의 대우크라이나 안전보장 참여 등을 희망하고 있는 것으로 전해졌습니다.
트럼프 미국 대통령의 중동 담당 특사인 스타브 위트코프는 이번 주 러시아를 방문해 블라디미르 푸틴 러시아 대통령과 만날 예정입니다.
신주원 PD
#우크라이나전쟁
연합뉴스TV 기사문의 및 제보 : 카톡/라인 jebo23
신주원(nanjuhee@yna.co.kr)